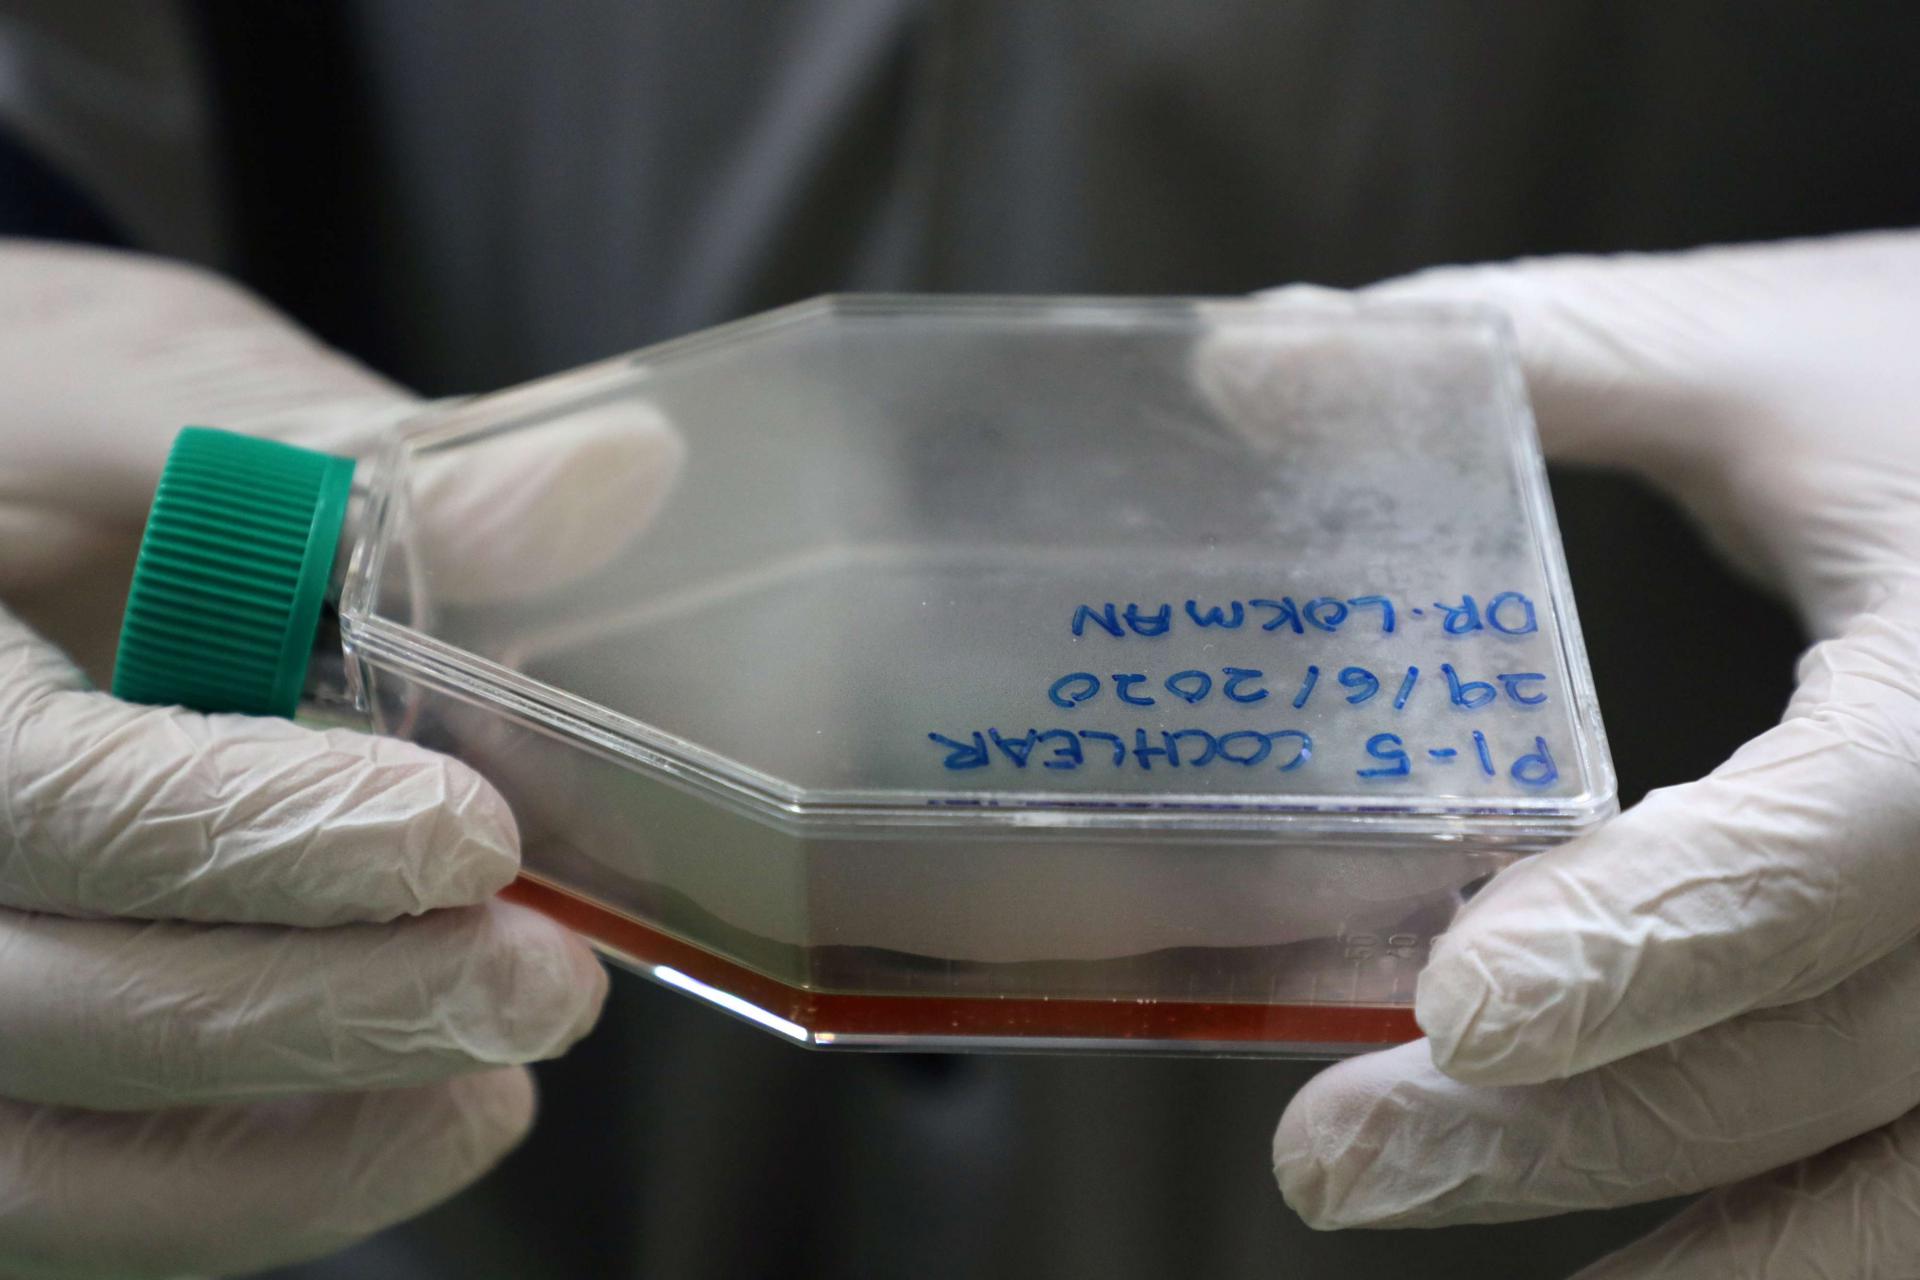
خلايا وحيد القرن السومطري

وحيد القرن الماليزي يتوثب لمغادرة قائمة الحيوانات المنقرضة
كوانتان (ماليزيا) - قطع من الجلد وبويضات وعينات أنسجة..هذا كل ما تبقى من إيمان، آخر انثى وحيد قرن في ماليزيا والتي نفقت في نوفمبر/تشرين الثاني الماضي بعد محاولات تكاثر فاشلة على مدى أعوام.
والآن يعلق العلماء آمالهم على تكنولوجيا خلايا جذعية تجريبية في استعادة السلالة الماليزية من حيوان وحيد القرن السومطري باستخدام خلايا مأخوذة من إيمان وحيوانين آخرين نافقين.
وقال خبير علم الأحياء الجزيئي محمد لقمان لرويترز في معمله بالجامعة الإسلامية العالمية في ماليزيا "أنا واثق جدا...إذا مضى كل شيء على نحو جيد ودعمنا الجميع فلن يكون ذلك مستحيلا".
ووحيد القرن السومطري وهو الأصغر حجما بين سلالات وحيد القرن وأعُلن انقراضه من البرية في ماليزيا في 2015. وكانت قطعانه تجوب أنحا ءآسيا في وقت ما لكن تراجعت أعداده إلى 80 فقط في إندونيسيا المجاورة بسبب الصيد وإزالة الغابات.
ونفقت إيمان وعمرها 25 عاما في محمية طبيعية في جزيرة بورنيو بعدما فقدت كمية هائلة من الدم نتيجة الإصابة بأورام في الرحم بعد ستة شهور من وفاة تام، آخر ذكر وحيد قرن في ماليزيا.
ولم تفلح جهود تزاوجهما.

ويعتزم العلماء الماليزيون استخدام خلايا من الحيوانات النافقة لإنتاج حيوانات منوية وبويضات ينتج عن تخصيبها أجنة أنابيب يجري زرعها بعد ذلك في حيوان حي أو سلالات قريبة من وحيد القرن السومطري مثل الخيول.
وتشبه هذه الخطة واحدة أخرى كانت تهدف لتكاثر وحيد القرن الأبيض الشمال أفريقي الذي لم يبق منه سوى اثنين فقط. وأعلن الباحثون في هذه التجربة إحراز بعض النجاح في 2018 وإنتاج خلايا جذعية جنينية لحيوان وحيد القرن الأبيض الجنوبي.
لكن العالمين توماس هيلدبرانت وسيزار جالي اللذين يقودان فريق الأبحاث قالا إن الطريق لا يزال طويلا أمام إنتاج حيوان جديد كامل.
وقال جالي إنه حتى إذا نجحت العملية فقد تشكل قلة التنوع الجيني للحيوان تهديدا على قدرته على العيش في المدى الطويل.
وقال عارف بوديونو العالم الإندونيسي الذي يساعد ماليزيا في مسعاها "قد يستغرق الأمر خمسة أو عشرة أو عشرين عاما لا أعلم، لكن تم بالفعل تحقيق بعض النجاح مع فئران التجارب في اليابان لذا قد تكون هناك فرصة".
وفي الوقت الراهن سيجري حشو جسد إيمان المفرغ وستعرض مع تام في أحد متاحف بورنيو.